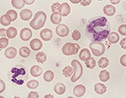

热点焦聚
- 感染尖锐湿疣需要注意什么
- 很多人都知道感染上尖锐湿疣应该及时到医院去治疗,但是却没有想过该病仅仅依靠医生的治疗是不够的,因为临... 详细→
- 前列腺疾病中心
Prostate Disease Center
- 性功能障碍中心
Sexual Dysfunction Center
- 性传播疾病中心
Sexually Transmitted Disease
- 生殖整形诊疗中心
Reproductive surgery clinics
- 生殖感染诊疗中心
Genital infection treatment
- 男性不育诊疗中心
Male Infertility Treatment

- [前列腺炎]引起前列腺炎的原因都有哪些
- [前列腺炎]慢性前列腺炎该如治疗
- [前列腺增生]患上前列腺增生的原因都有哪些
- [前列腺炎]前列腺炎真的会影响生育吗
- [前列腺炎]前列腺炎发生的原因有哪些
- [前列腺增生]前列腺增生早期症状有哪些
- [前列腺肥大]前列腺肥大的治疗有哪些注意事项
- [前列腺炎]前列腺炎的治疗注意事项有什么
- [前列腺炎]前列腺炎会引发小腹胀痛吗

- [阳痿]阳痿可以自己恢复吗
- [勃起障碍]得了勃起功能障碍疾病吃什么药
- [早泄]早泄的危害有哪些
- [早泄]早泄主要有哪些表现
- [阳痿]治阳痿的效果怎么样
- [阳痿]阳痿对男性将会造成哪些影响
- [射精障碍]预防射精无力要记住几点
- [阳痿]阳痿对男性会造成哪些危害
- [早泄]哪些疾病会引起早泄
- [过度手淫]手淫一定会造成阳痿吗
- [阳痿]男性患有哪些疾病会出现阳痿
- [早泄]哪些内因会导致男性早泄

- [尖锐湿疣]感染尖锐湿疣需要注意什么
- [梅毒]梅毒的护理方法
- [生殖器疱疹]怎么预防感染生殖器疱疹
- [尖锐湿疣]尖锐湿疣可以根治吗
- [女性性病]非淋菌性尿道炎需要了解的相关知
- [梅毒]梅毒要怎么吃药治疗比较好
- [非淋]在治疗非淋菌性尿道炎时要注意些
- [生殖器疱疹]得了生殖器疱疹还能生孩子吗
- [淋病]怎样避免尖锐湿疣复发
- [尖锐湿疣]尖锐湿疣的日常护理
- [生殖器疱疹]做完生殖器疱疹手术后怎么注意
- [尖锐湿疣]尖锐湿疣能不能根治

- [包皮过长]包皮手术后要怎么护理好得快
- [阴茎增粗]男人阴茎增粗手术后需要注意什么
- [阴茎延长]阴茎延长手术后要注意哪些护理
- [包皮过长]男性进行包皮手术的好处有哪些
- [包皮过长]男生包皮过长需要进行手术吗
- [包茎]包皮包茎的危害是什么
- [包皮过长]包皮过长不割有什么危害
- [阴茎增粗]阴茎增粗吃什么
- [包皮过长]割包皮过长挂什么科

- [睾丸炎]患上睾丸炎的原因都有哪些
- [尿道炎]尿道炎的危害有哪些
- [龟头炎]龟头痒是怎么了
- [精囊炎]怎么预防精囊炎
- [尿道炎]尿道炎反复发作该怎么办
- [睾丸炎]睾丸炎会导致睾丸下垂吗
- [龟头炎]龟头里面有白的异物还有点发痒是
- [尿道炎]哪些坏习惯引起了尿道炎
- [睾丸炎]睾丸炎的原因有哪些

- [无精]患上无精症具体有哪些方面的危害
- [男性不育症]男性的精液变黄是怎么回事
医院环境